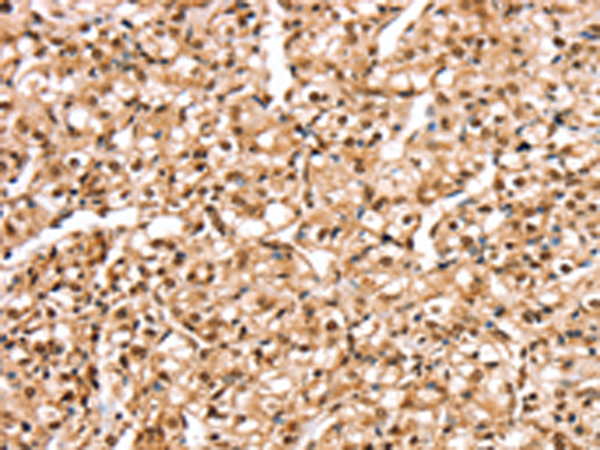

-
分类: 科研抗体货号: P12256别名: HI; SUR; HHF1; MRP8; PHHI; SUR1; ABC36; HRINS; TNDM2; SUR1delta2应用: IHC反应种属: Human, Rat
-
分类: 科研抗体货号: P12238别名: NEAS; EIEE5; SPTA2应用: IHC反应种属: Human, Mouse, Rat
-
分类: 科研抗体货号: P12255别名: SULF-1应用: IHC反应种属: Human, Mouse, Rat
-
分类: 科研抗体货号: P12237别名:应用: WB,IHC反应种属: Human
-
分类: 科研抗体货号: P12254别名: MGST; GST12; MGST-I应用: IHC反应种属: Human
-
分类: 科研抗体货号: P12236别名: Mieap; SPETEX1应用: WB反应种属: Human
-
分类: 科研抗体货号: P12253别名: PKE; YANK3应用: IHC反应种属: Human, Mouse
-
分类: 科研抗体货号: P12235别名: SC1; MAST9; PIG33; MAST 9应用: IHC反应种属: Human
-
分类: 科研抗体货号: P12252别名: STK32; STKG6; YANK2; HSA250839应用: IHC反应种属: Human
-
分类: 科研抗体货号: P12232别名: SODD; BAG-4应用: WB反应种属: Human, Mouse

鄂公网安备42018502007531号
鄂公网安备42018502007531号

